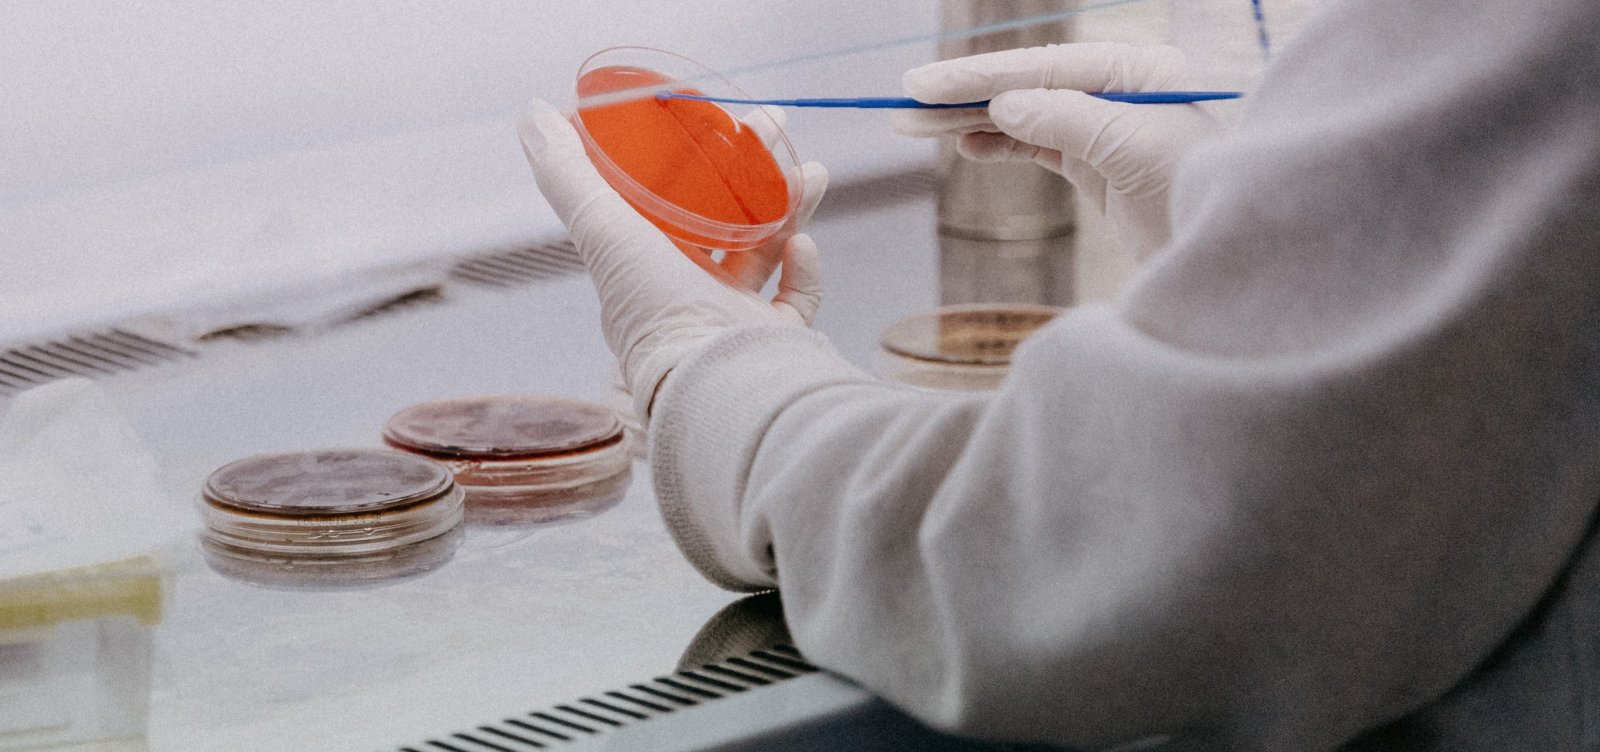
Anestesista critica defesa do tratamento precoce: 'Fundamental é nós nos iluminarmos pela ciência'

Saúde
Anestesista critica defesa do tratamento precoce: 'Fundamental é nós nos iluminarmos pela ciência'
"Ivermectina não tem eficácia no tratamento precoce", disse dr. Túlio Alves, que também defende lockdown
Foto: Trnava University/Unsplash
O médico Túlio Alves, anestesista e professor de farmacologia, falou sobre tratamento precoce em entrevista a José Eduardo hoje (22), durante o Jornal da Bahia no Ar da Rádio Metrópole. "O fundamental é nós nos iluminarmos pela ciência", destacou o profissional de saúde. "Gostaria muito enquanto farmacologista que todas essas medicações inventadas tivessem eficácia", disse o médico. No entanto, ele reforçou que são necessários diversos testes para garantir que os medicamentos apresentam efeitos satisfatórios nos pacientes. "Para receber o selo de que são efetivos, eles tem que passar por testes. Uma são os ensaios clínicos: nada mais é do que testar uma substância contra outra que não tem efeito nenhum, um placebo. Se nós acharmos um resultado positivo, esse resultado tem que ser validado por outros grupos para afirmar se o medicamento tem validade ou não", explicou.
Dr. Túlio reforçou que, embora alguns médicos tenham defendido o tratamento precoce, não há estudos validados que comprovem a eficácia de medicamentos como ivermectina e hidroxicloroquina. "Nenhuma desses medicamentos teve o estudo validado. O contrário nós já temos. [...] Ivermectina não tem eficácia no tratamento precoce", disse o professor.
Ainda de acordo com o anestesista, a melhor maneira de evitar quebrar o país ou o mundo, é vacinar a população mundial. Para isso, além da campanha de imunização, ele defende a adoção de medidas enérgicas por parte dos governantes. "Em alguns momentos, quando nossas unidades estão lotadas, como é o caso, alguns estados em situação difícil, nesses casos o lockdown é fundamental. Ele não vai se colocar contra a economia, muito pelo contrário. O que se quer é diminuir a circulação do vírus. O lockdown é uma ferramenta que deve ser introduzida em determinados momentos", afirmou.
"Não são as medidas restritivas, inclusive o lockdown, que vai quebrar a economia, muito pelo contrário. Quem está quebrando a economia é a morosidade, é a falta de políticas acertadas. O Ministério da Saúde tem que assumir a condição de maestro, dar um caráter mais regular, mais harmônico. [...] Não há uma política certeira, as políticas do Ministério da Saúde são todas erráticas. Essa falta de sincronia, de equilíbrio, pra nós resolvermos agora esse problema", acrescentou o médico.
📲 Clique aqui para fazer parte do novo canal da Metropole no WhatsApp.

